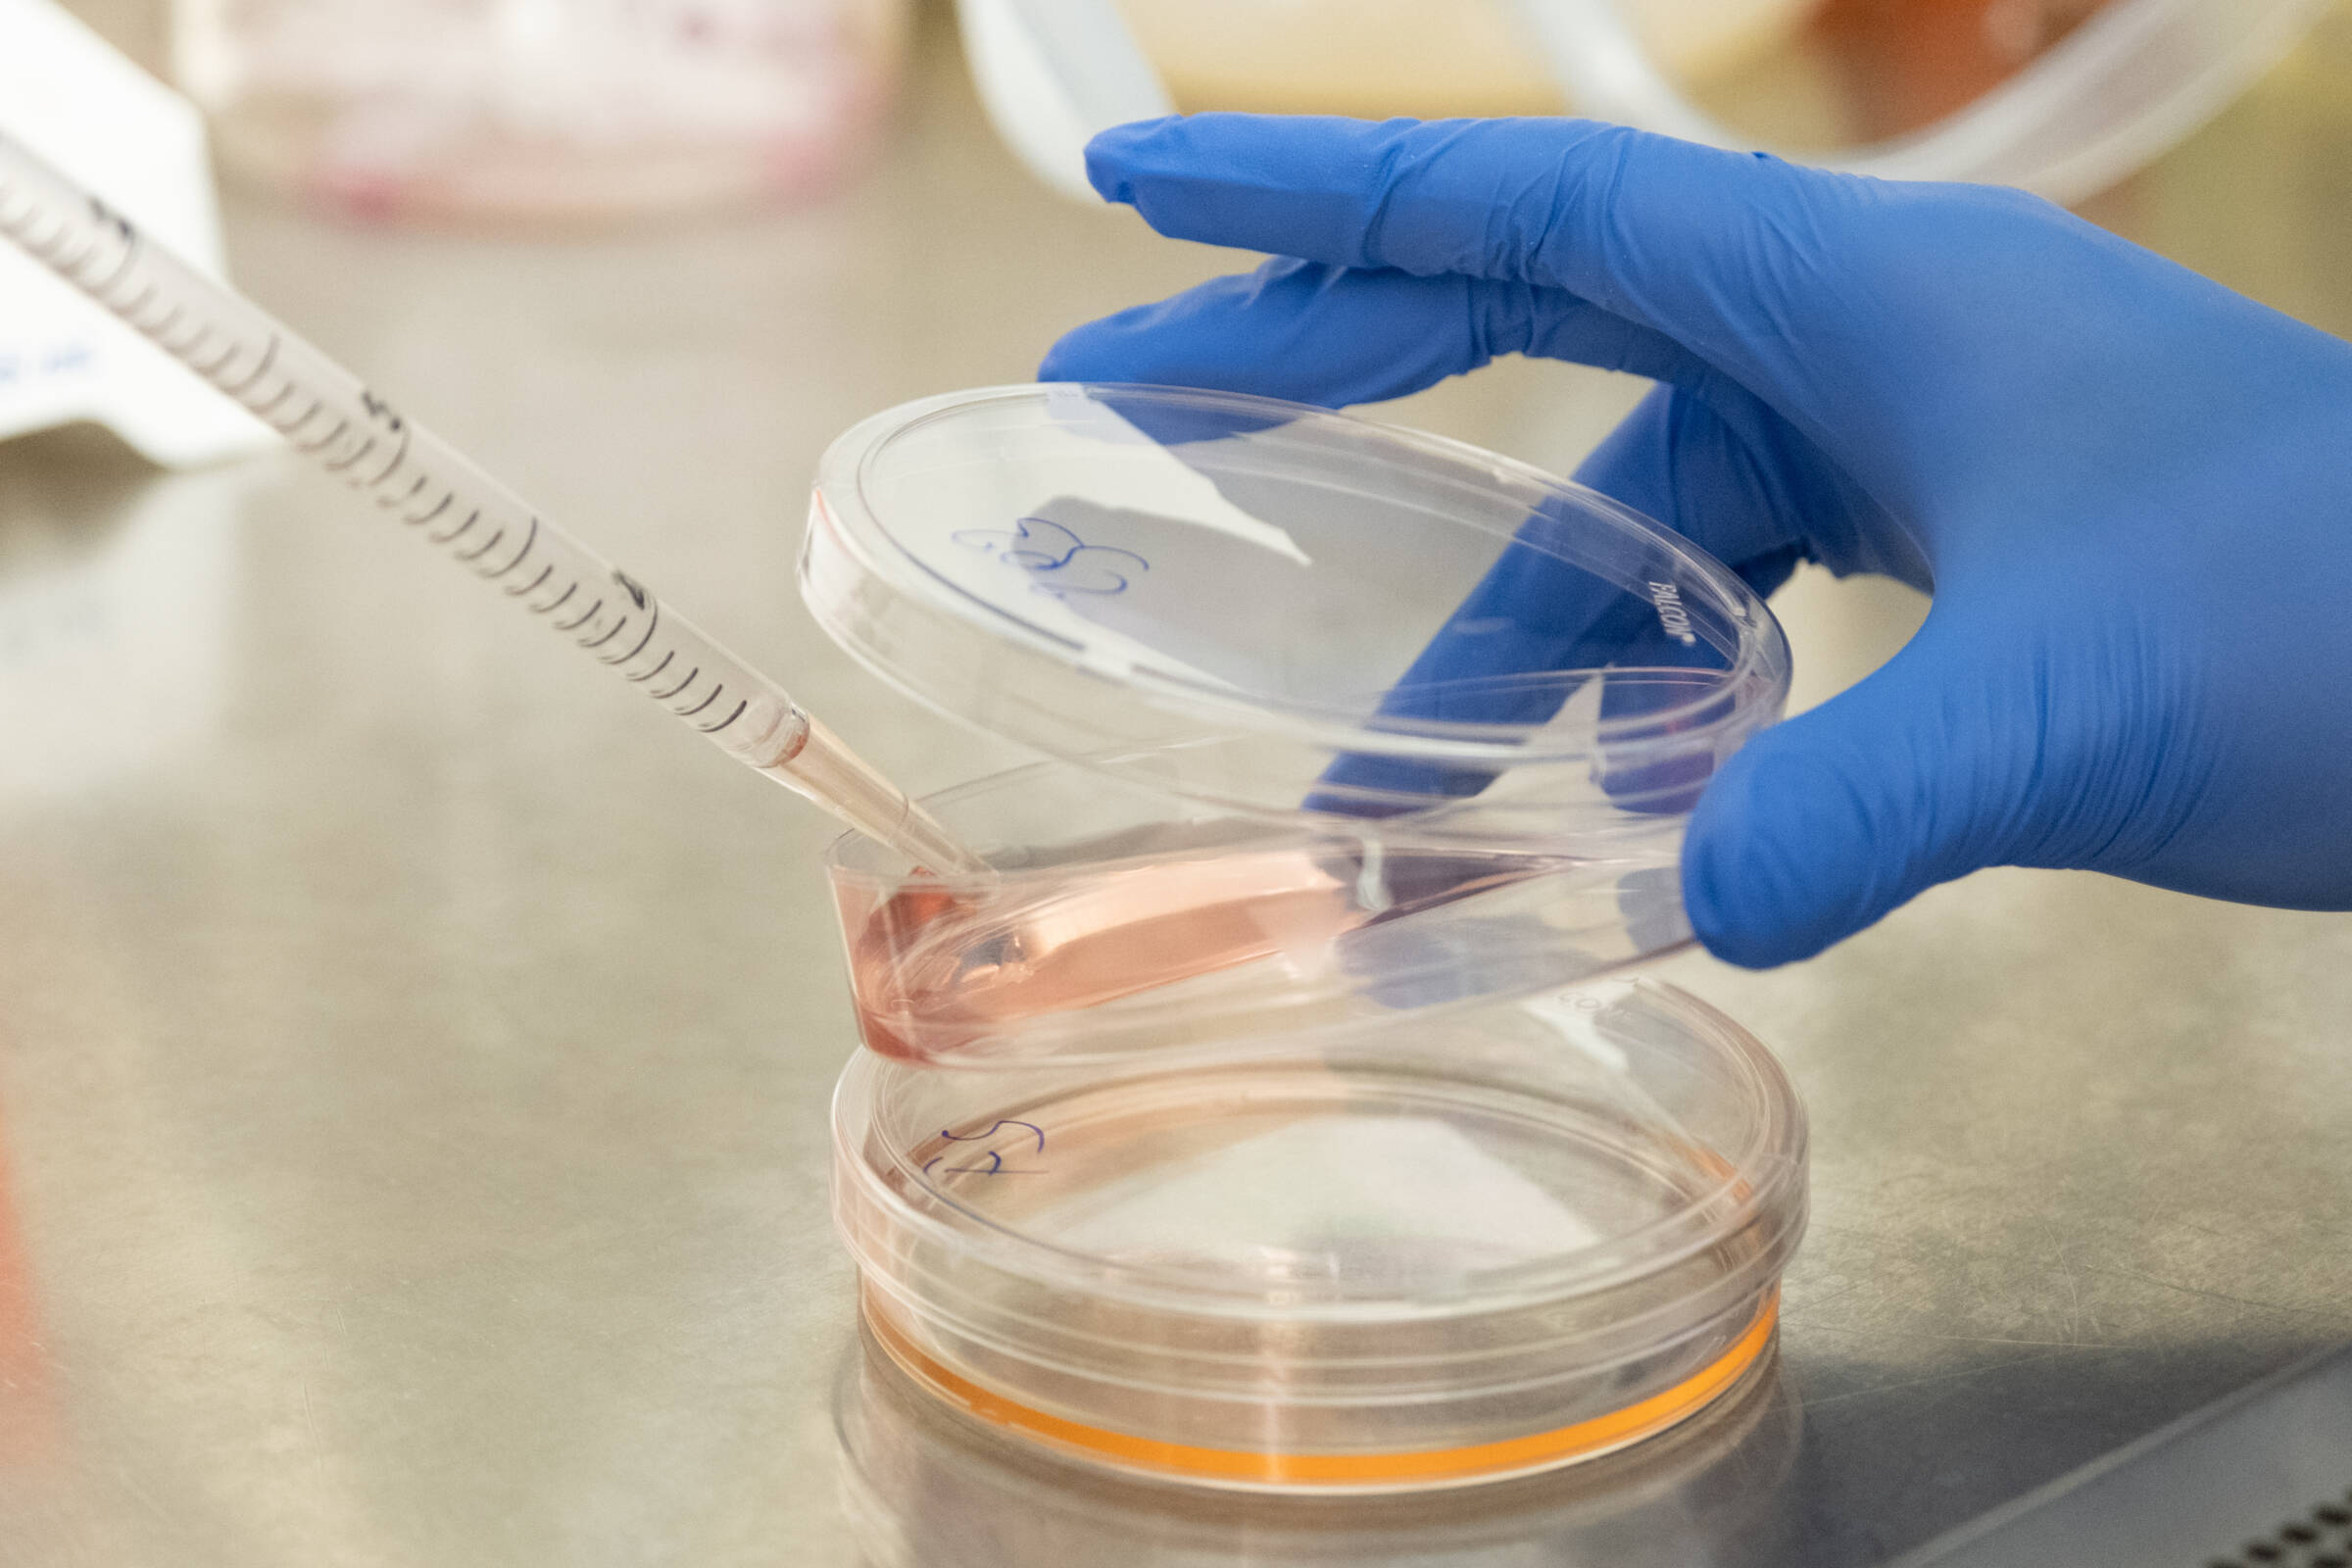
The Rockefeller University » News & Highlights

Die Rockefeller University ist eine Universität in New York City. Sie befindet sie sich zwischen der 63. und der 68. Straße an der York Avenue in der Upper East Side von Manhattan. Die Rockefeller University hat ihren Schwerpunkt in Forschung und Lehre im biomedizinischen Bereich. Studenten können den Abschluss eines Berufsdoktorates der Medizin oder eines Ph.D. erwerben. Zudem gibt es Forschungsstellen für Post-Doktoranden.
Geschichte
Die Anfänge der Hochschule liegen zum Teil in einer persönlichen Tragödie. Nachdem John D. Rockefeller Sr.s Enkel im Januar 1901 an Scharlach gestorben war, wurden die über drei Jahre hingezogenen Planungen von Frederick T. Gates und John D. Rockefeller Jr. für den Aufbau eines Forschungsinstituts schnell verwirklicht. Als Vorbild dienten Forschungszentren in Europa, wie die Robert-Koch- und Pasteur-Institute. Zum Zeitpunkt der Gründung 1901 des Rockefeller Institute for Medical Research wurden die Infektionskrankheiten wie Scharlach, Masern, Tuberkulose, Diphtherie und Typhus als die größten bekannten Bedrohungen für die menschliche Gesundheit angesehen. Zunächst erhielt das Institut den Auftrag, um u. a. Probleme der öffentlichen Gesundheit wie die bakterielle Kontamination der Milch in New York City zu untersuchen.
Nach zwei Jahren im Ausweichquartier wurden im Jahr 1906 die Labore auf dem Gelände des ehemaligen Schermerhorn Bauernhof an der York Avenue (damals Avenue A) und 66th Street eröffnet. Von Anfang an machten Rockefeller Wissenschaftler wichtige Beiträge zum Verständnis und Heilung von Krankheiten. Simon Flexner, der erste Direktor des Instituts, entwickelte ein innovatives Trägersystem für ein Anti-Serum gegen Meningitis; Hideyo Noguchi studierte die Syphilis Mikrobe und suchte nach der Ursache von Gelbfieber; Louise Pearce entwickelte ein Medikament gegen die Afrikanische Schlafkrankheit und Peyton Rous entdeckte, dass Krebs durch ein Virus verursacht werden kann.
1910 wurde das Rockefeller Hospital gegründet als erstes Krankenhaus in den USA, das sich ausschließlich der klinischen Forschung widmete. Überzeugt davon, dass der medizinische Fortschritt sowohl durch Laborforschung als auch durch die Erforschung von Krankheiten im Krankenhaus den Patienten zugutekommen würde, wurden die besten Köpfe rekrutiert – darunter Ärzte, Chemiker, Mikrobiologen, Virologen, Immunologen und Neurologen. Das Rockefeller Institute Hospital war von entscheidender Bedeutung für die Aufgaben des Instituts. Als erstes Zentrum für klinische Forschung in den Vereinigten Staaten bleibt es ein Ort, an dem Forscher Laboruntersuchungen mit Beobachtungen am Krankenbett verknüpfen können, um wissenschaftliche Grundlagen für Krankheit, Vorbeugung und Behandlung zu ermöglichen. Neben anderen Krankheiten untersuchten die Forscher schon früh im Krankenhaus Polio, Herzkrankheiten und Diabetes. Eine neue Art von Wissenschaftlern entstand aus diesem wegweisenden Modell des Forschungshospitals: Der klinische Forscher, der als Bindeglied zwischen dem praktizierenden Arzt und dem grundlegenden Wissenschaftler dient.
Einige andere wichtige Beiträge umfassen die Entwicklung der Sauerstoffkammer, Grippeimpfung, Blutchemieanalyse nach Van Slyke, Methoden zur Bluttransfusion und zur Lagerung von Blut, diagnostische Tests für die Bleivergiftung, neue Therapien zur Behandlung von Psoriasis und mehrere medikamentöse Therapien der HIV-Infektion sowie die detaillierte Charakterisierung zahlreicher Krankheiten, u. a. von Poliomyelitis, Morbus Wilson und Porphyrie.
Nach der Aufnahme des Lehrbetriebs wurde das Institut 1965 in Rockefeller University umbenannt. Am 7. Oktober 2010 feierte die Universität das hundertjährige Bestehen ihres Krankenhauses.
Im Laufe seiner Geschichte konnte die Einrichtung 25 Nobelpreisträger hervorbringen.
Persönlichkeiten
Dozenten
- David Baltimore (* 1938), Präsident (1990 bis 1991), Virologe, Nobelpreis für Physiologie oder Medizin 1975
- Günter Blobel (1936–2018), Biochemiker, Nobelpreis für Physiologie oder Medizin 1999
- Theodosius Dobzhansky (1900–1975), Genetiker
- Christian de Duve (1917–2013), Biochemiker, Nobelpreis für Physiologie oder Medizin 1974
- Gerald M. Edelman (1929–2014), Mediziner, Nobelpreis für Physiologie oder Medizin 1972
- Mitchell Feigenbaum (1944–2019), Physiker
- Harry Frankfurt (1929–2023), Philosoph
- Paul Greengard (1925–2019), Biochemiker, Nobelpreis für Physiologie oder Medizin 2000
- Haldan Keffer Hartline (1903–1983), Physiologe, Nobelpreis für Physiologie oder Medizin 1967
- David Ho (* 1952), AIDS-Forscher
- Mark Kac (1914–1984), Mathematiker
- Joshua Lederberg (1925–2008), Präsident (1979 bis 1990), Molekularbiologe, Nobelpreis für Physiologie oder Medizin 1958
- Albert J. Libchaber (* 1934), Physiker
- Fritz Albert Lipmann (1899–1986), Biochemiker, Nobelpreis für Physiologie oder Medizin 1953
- Roderick MacKinnon (* 1956), Molekulare Neurobiologie und Biophysik, Nobelpreis für Chemie 2000
- Neal E. Miller (1909–2002), Psychologe und Neurowissenschaftler, Pionier der Biofeedback-Forschung
- Paul Nurse (* 1949), Präsident, Biochemiker, Nobelpreis für Physiologie oder Medizin 2001
- Frederick Seitz (1911–2008), Präsident (1968 bis 1979), Physiker
- Ralph Steinman (1943–2011), Immunologie-Forscher, Nobelpreis für Physiologie oder Medizin 2011
- Torsten N. Wiesel (* 1924), Präsident (1991 bis 1998), Nobelpreis für Physiologie oder Medizin 1981
Forschung
- Oswald Avery (1877–1955), Mediziner
- Alexis Carrel (1873–1944), Mediziner, Nobelpreis für Physiologie oder Medizin 1912
- Albert Claude (1899–1983), Zellbiologe, Nobelpreis für Physiologie oder Medizin 1974
- Herbert Spencer Gasser (1888–1963), Neurophysiologe, Nobelpreis für Physiologie oder Medizin 1944
- Karl Landsteiner (1868–1943), Pathologe und Serologe, Nobelpreis für Physiologie oder Medizin 1930
- Robert Bruce Merrifield (1921–2006), Chemiker, Nobelpreis für Chemie 1984
- Maclyn McCarty (1911–2005), Biologe
- Stanford Moore (1913–1982), Biochemiker, Nobelpreis für Chemie 1972
- John Howard Northrop (1891–1987), Chemiker, Nobelpreis für Chemie 1946
- George Emil Palade (1912–2008), Zellbiologe, Nobelpreis für Physiologie oder Medizin 1974
- Louise Pearce (1885–1959), Pathologin, entwickelte ein Medikament gegen die Afrikanische Schlafkrankheit
- Francis Peyton Rous (1879–1970), Pathologe, Nobelpreis für Physiologie oder Medizin 1966
- Wendell Meredith Stanley (1904–1971), Chemiker, Nobelpreis für Chemie 1946
- Richard Shope (1901–1966), Virologe
- William Howard Stein (1911–1980), Biochemiker, Nobelpreis für Chemie 1972
- Edward Lawrie Tatum (1909–1975), Genetiker, Nobelpreis für Physiologie oder Medizin 1958
- Thomas Tuschl (* 1966), Biochemiker und Molekularbiologe
- Knut Michael Wittkowski, Biostatistiker
Absolventen
- Barbara Ehrenreich (1941–2022), Sachbuch-Autorin und journalistische Kolumnistin
- Seth Lloyd (* 1960), Informatiker und Physiker, Professor am MIT
Weblinks
- The Rockefeller University (englisch)
- Rockefeller University Hospital
Einzelnachweise